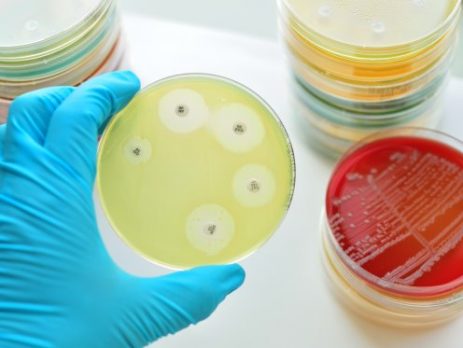

EU PIG PRICES: SLAUGHTER COMPANIES ARE PUSHING DOWN THE PRICES
Quite contrary to the current weather conditions, the mood is rather frosty on the EU pigs-mature-for-slaughter markets these days. On the part of the slaughter companies, demand is very restrained for pigs for slaughter with the quantities on offer [...]